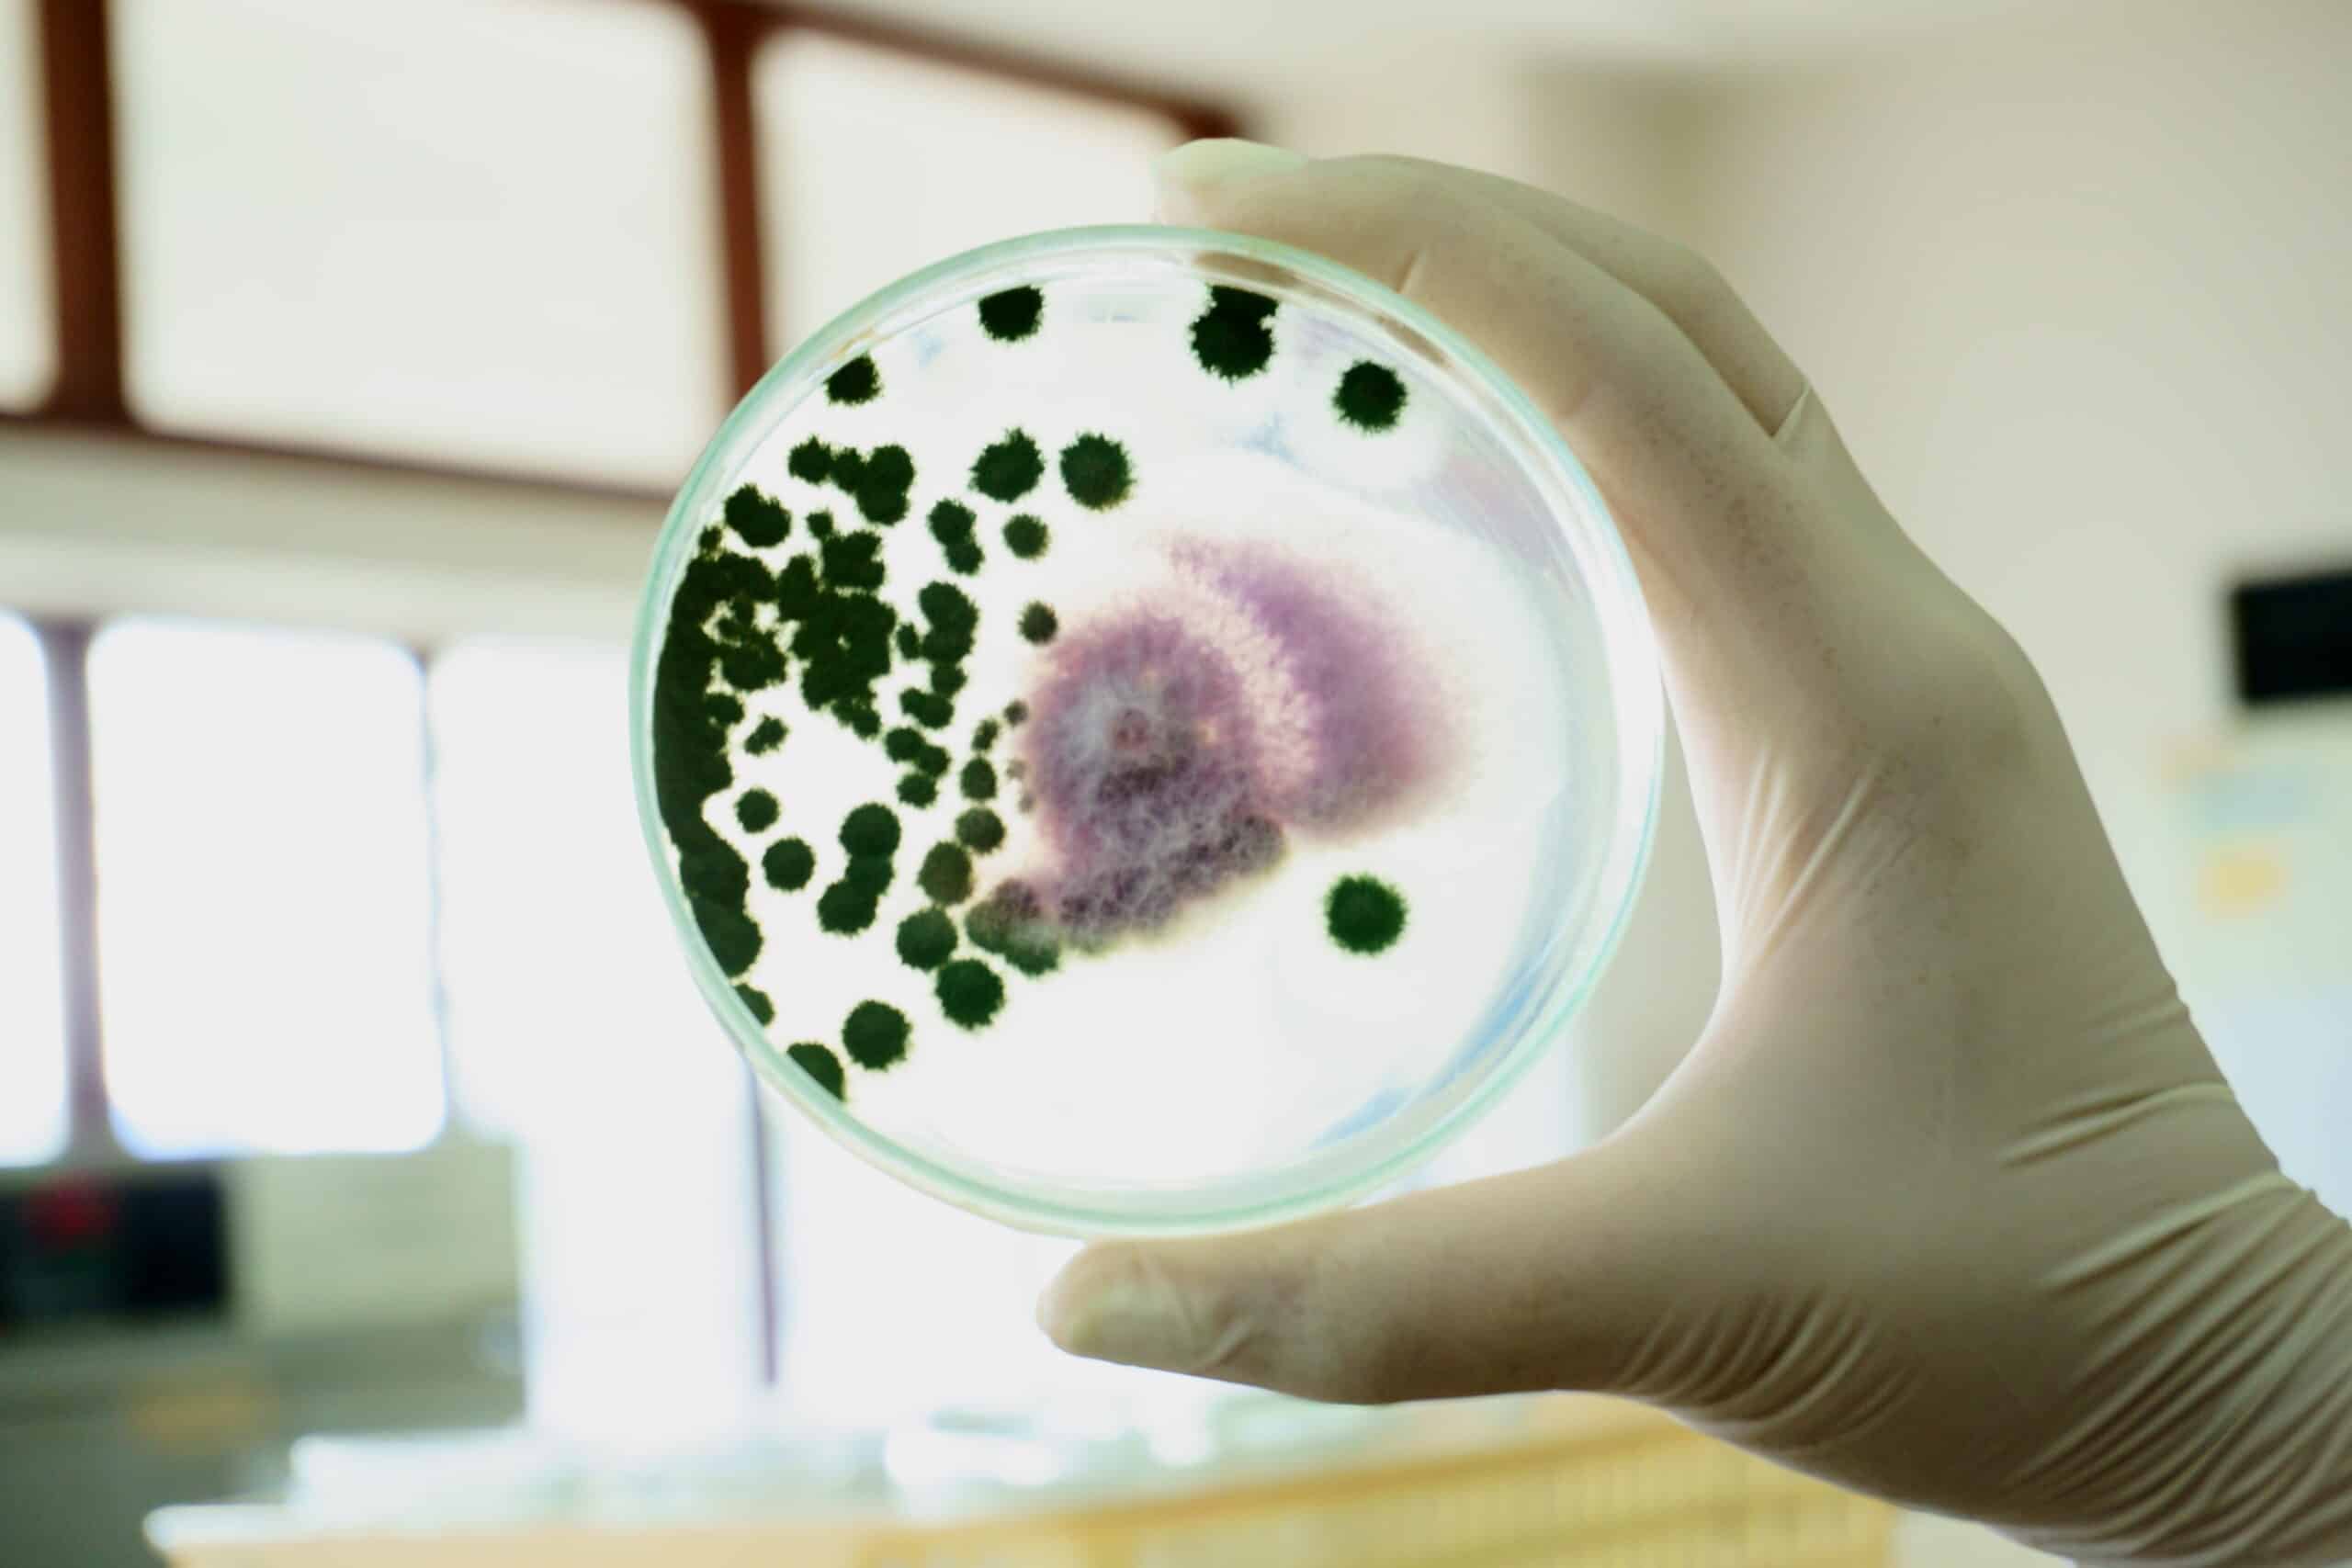

De kans is aanwezig dat je al wel eens van biologische agentia hebt gehoord, maar misschien weet je nog niet precies wat het inhoudt. Biologische agentia zijn alle soorten organismen die mensen, dieren, planten en bomen ziek kunnen maken.
Waar kom je ze tegen?
Biologische agentia zijn in principe overal te vinden. Ook op de werkplek komen ze dus voor. Als je in contact komt met biologische agentia kun je hier (langdurig) ziek van worden. Net als bij blootstelling aan gevaarlijke stoffen, moeten de risico’s in kaart worden gebracht.
Het 4-stappen plan
De onderstaande 4 stappen zijn de basis voor het beheersen van de risico’s van het werken met biologische agentia.
Het in kaart brengen, inventariseren, van biologische agentia kan op verschillende manieren. In sommige gevallen is het duidelijk met welke agentia je te maken hebt. Denk maar aan een laboratorium waar onderzoek wordt gedaan naar specifieke bacteriën, schimmels of virussen. Maar in veel gevallen is het niet duidelijk welke agentia er aanwezig zijn. Denk aan een afvalverwerkingsbedrijf waar allemaal verschillende materialen verwerkt worden. Hier kun je heel verschillende soorten agentia tegen komen.
Als je weet welke soorten biologische agentia een mogelijk gevaar vormen, moet je de risico’s nog vaststellen. Door de blootstelling in kaart te brengen kun je dit beoordelen. Zo’n beoordeling kun je doen door gebruik te maken van metingen. Ook zijn er modellen beschikbaar waarmee een kwalitatieve beoordeling gemaakt kan worden.
Uit de beoordeling volgt of er maatregelen genomen moeten worden. Het nemen van maatregelen moet volgens de arbeidshygiënische strategie, ook wel STOP-strategie, worden uitgevoerd. De STOP-strategie schrijft voor welke soort maatregelen er genomen kunnen worden. Ook schrijft het voor in welke volgorde de maatregelen genomen moeten worden.
Vervolgens moet dit proces goed worden geborgd in de praktijk. Als er veranderingen zijn in een van de vorige stappen moeten (een deel van) de stappen opnieuw worden uitgevoerd. Het geven van de juiste werkinstructies, voorlichting en training aan medewerkers hoort ook bij de borging.
Meer weten of vragen?
Wil je meer weten over biologische agentia en het beheersen van de risico’s? Neem dan vooral contact met ons op via info@paltrock.com of bel naar 030-2520345.
Via onze Academy en opleidingen kunt u meer leren over huidblootstelling en de beheersing van de risico’s op de werkvloer.
Volg ons ook via LinkedIn om op de hoogte te blijven van alle ontwikkelingen!